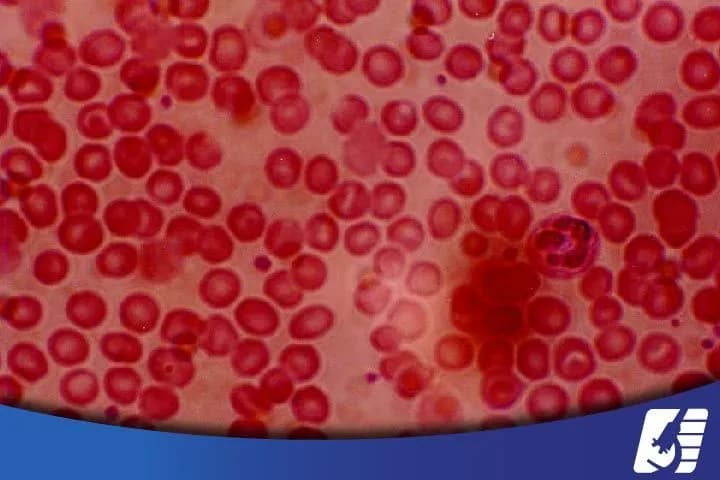
biometria-hematica

En la unidad realizamos estudios de laboratorio que permitan identificar un diagnóstico más acertado de los padecimientos de nuestros pacientes, de manera que podamos ofrecer el tratamiento adecuado.

Esta práctica se realiza para ver qué tipo de células están presentes en el moco nasal y brinda orientación para identificar si el problema es de tipo infeccioso, alérgico o su combinación.

Otro de los estudios que sirven para identificar a qué es alérgica una persona, es el perfil inflamatorio, éste es una toma de sangre que permite obtener hasta 36 posibles agentes alérgicos.
Es un estudio que consiste en que examinar las células que componen la sangre, ofrece una información general de la sangre y sus componentes, puede mostrar alteraciones o enfermedades hematológicas, o bien, una alteración indirecta de una enfermedad de algún otro órgano.